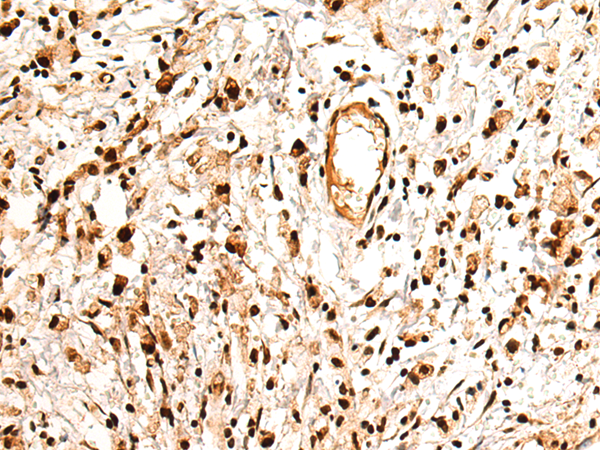

中文名稱: 兔抗PTBP2多克隆抗體
英文名稱: Anti-PTBP2 rabbit polyclonal antibody
別 名: polypyrimidine tract binding protein 2; nPTB; PTBLP; brPTB
相關(guān)類別: 一抗
儲(chǔ) 存: 冷凍(-20℃)
宿 主: Rabbit
抗 原: PTBP2
反應(yīng)種屬: Human, Mouse, Rat
標(biāo) 記 物: Unconjugate
克隆類型: rabbit polyclonal
技術(shù)規(guī)格
|
Background: |
The protein encoded by this gene binds to intronic polypyrimidine clusters in pre-mRNA molecules and is implicated in controlling the assembly of other splicing-regulatory proteins. This protein is very similar to the polypyrimidine tract binding protein (PTB) but most of its isoforms are expressed primarily in the brain. Alternative splicing results in multiple transcript variants. |
|
Applications: |
ELISA, WB, IHC |
|
Name of antibody: |
PTBP2 |
|
Immunogen: |
Fusion protein of human PTBP2 |
|
Full name: |
polypyrimidine tract binding protein 2 |
|
Synonyms: |
nPTB; PTBLP; brPTB |
|
SwissProt: |
Q9UKA9 |
|
ELISA Recommended dilution: |
5000-10000 |
|
IHC positive control: |
Human gastric cancer |
|
IHC Recommend dilution: |
100-300 |
|
WB Predicted band size: |
57 kDa |
|
WB Positive control: |
Mouse testis tissue, Hela cell, LOVO cell, HepG2 cell lysates |
|
WB Recommended dilution: |
1000-5000 |

購(gòu)物車
幫助
021-54845833/15800441009
